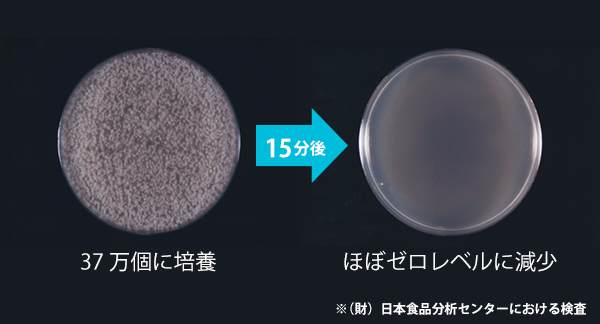
紫外線による99.9%除菌

ヒトの足の裏は、
左右合わせて一日に
コップ一杯もの汗を
かくと言われています。
湿った靴の中は、雑菌の温床に……




リフレッシューズなら、
3つの能力を同時に作用
臭いの原因をすべて解決します!

二酸化チタン光触媒の強力な酸化作用により、悪臭の主成分「イソ吉草酸」をダイレクトに分解し、靴のイヤな匂いを脱臭。

紫外線の照射により白癬菌(水虫菌)や黄色ブドウ球菌の他、カビや様々な雑菌を99.9%除菌。

デリケートな革靴にもダメージを与えにくい優しい温風で、ムレを乾燥し菌の再繁殖を防ぎます。
リフレッシューズは
確かな効果のために
以下の方式・方法は
利用していません。



密閉された水槽など特別に
用意された環境ではなく、
リフレッシューズは市販の靴を使用し、
実使用環境で検証しました。
紫外線の照射により白癬菌(水虫菌)や黄色ブドウ球菌の他、カビや様々な雑菌を99.9%除菌。

脱臭試験により30分程度で新品の靴の臭いまで脱臭されることが証明されています。

超キレイ好きでも有名なひろみちお兄さんのご自宅で、お使いいただいているところをご紹介いただきました。

高級リゾートとしても有名な星野リゾートを運営する星のや様で、お客様への更に一歩進んだサービスとして、ご採用いただいているとのご紹介をいただきました。
明日のヒット商品を探し出し、ドランクドラゴンのお二人と研究助手の皆さんが面白おかしく紹介する!
BS12 バカ売れ研究所様にて、リフレッシューズが紹介されました。


97%のお客様にご満足をいただき、また「非常に不満」とお答えになったお客様は0人!

93%のお客様にご満足をいただき、また「非常に不満」とお答えになったお客様は0人!

今まで乾燥しかしない物を使用していましたが、いまいち乾燥しきれなく、臭いなどが消えませんでした。知人からこの商品の事を聞き購入してもらい使用しています。
乾燥だけで無く、除菌・消臭を同時に出来るのは驚きました。
ものすごい効果を発揮しているのが毎日感じます。
現在、自宅で使用していますが会社にももう一台置きたく購入する事に決めました。
やっと届きました。2台目の購入です。
1台目がすごくよかったので再度購入しょうと思ったらテレビでタレントの方が紹介されたため2台目がなかなか手に入りませんでした。
毎日、靴の除菌と乾燥をしています。(靴にも1日ご苦労様の気持ちで・・・)翌日も気持ちよく仕事に履いて行けます。
おすすめです。

さすが、の脱臭・殺菌能力ですネ。
革靴の内側のつま先部に青カビが生えてしまい、靴用乾燥機を探していたところ、性能がよさそうだったので購入しました。
カビを取り除いた後、60分間乾燥し、一日寝かせてから履いてみましたが、カビが再び生えることはありませんでした。
他社商品が壊れたため購入しました。
大きさがコンパクトで持ち運び・使い勝手がとても良いです。
夜に使用し、次の日の朝履くと毎回新品の靴のように爽やかに履けます。
靴が、じめじめ感なし、臭い少なし、清潔感あり、になります。
履いたその日に使うと、乾燥中の臭いが気になりますので、
2足使いまわす使用方法をお勧めします。お勧めです!

| 電源 | AC100V 50/60Hz |
|---|---|
| 消費電力 | 80w |
| 運転モード | 15分、30分、60分の3段階 |
| 安全対 | センサースイッチによる自動消灯 |
| サイズ 保管時 | W220 X D275 X H73 |
| サイズ 使用時 | W220 X D275 X H255~300 |
| 重量 | 1.2㎏ |
| 材料 | ASA |
| ロングブーツ | × |
|---|---|
| ショートブーツ | ○ |
| サンダル | ○ |
| ミュール | ○ |
| ビジネスシューズ | ○ |
| スニーカー | ○ |
| スキー靴など | × |
| ハイカットシューズ | △ |
| 電源 | AC100V 50/60Hz |
|---|---|
| 消費電力 | 80w |
| 運転モード | 15分、30分、60分の3段階 |
| 安全対 | センサースイッチによる自動消灯 |
| サイズ 保管時 | W220 × D275 × H73 |
| サイズ 使用時 | W220 × D275 × H255~300 |
| 重量 | 1.2㎏ |
| 材料 | ASA |
| ロングブーツ | × |
| ショートブーツ | ○ |
| サンダル | ○ |
| ミュール | ○ |
| ビジネスシューズ | ○ |
| スニーカー | ○ |
| スキー靴など | × |
| ショートブーツ/ハイカットシューズ | △ |